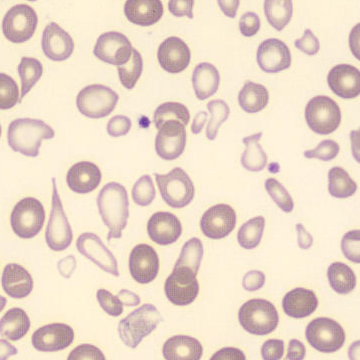

RET - Transfusion
FSC
SFL
Érythrocytes
Réticulocytes
Fragments de RBC
Ce nuage de points montre deux populations. L'une élevée sur l'axe des ordonnées et l'autre basse sur l'axe des ordonnées . Cette image est observée chez les patients dont la numération sanguine est microcytaire (par exemple en raison d'une carence en fer) et qui reçoivent une transfusion sanguine. Les érythrocytes du donneur ont une taille normale. Au microscope, on peut observer un mélange d'érythrocytes petits et vides et d'érythrocytes normaux et bien remplis (dimorphisme).
Morphologie